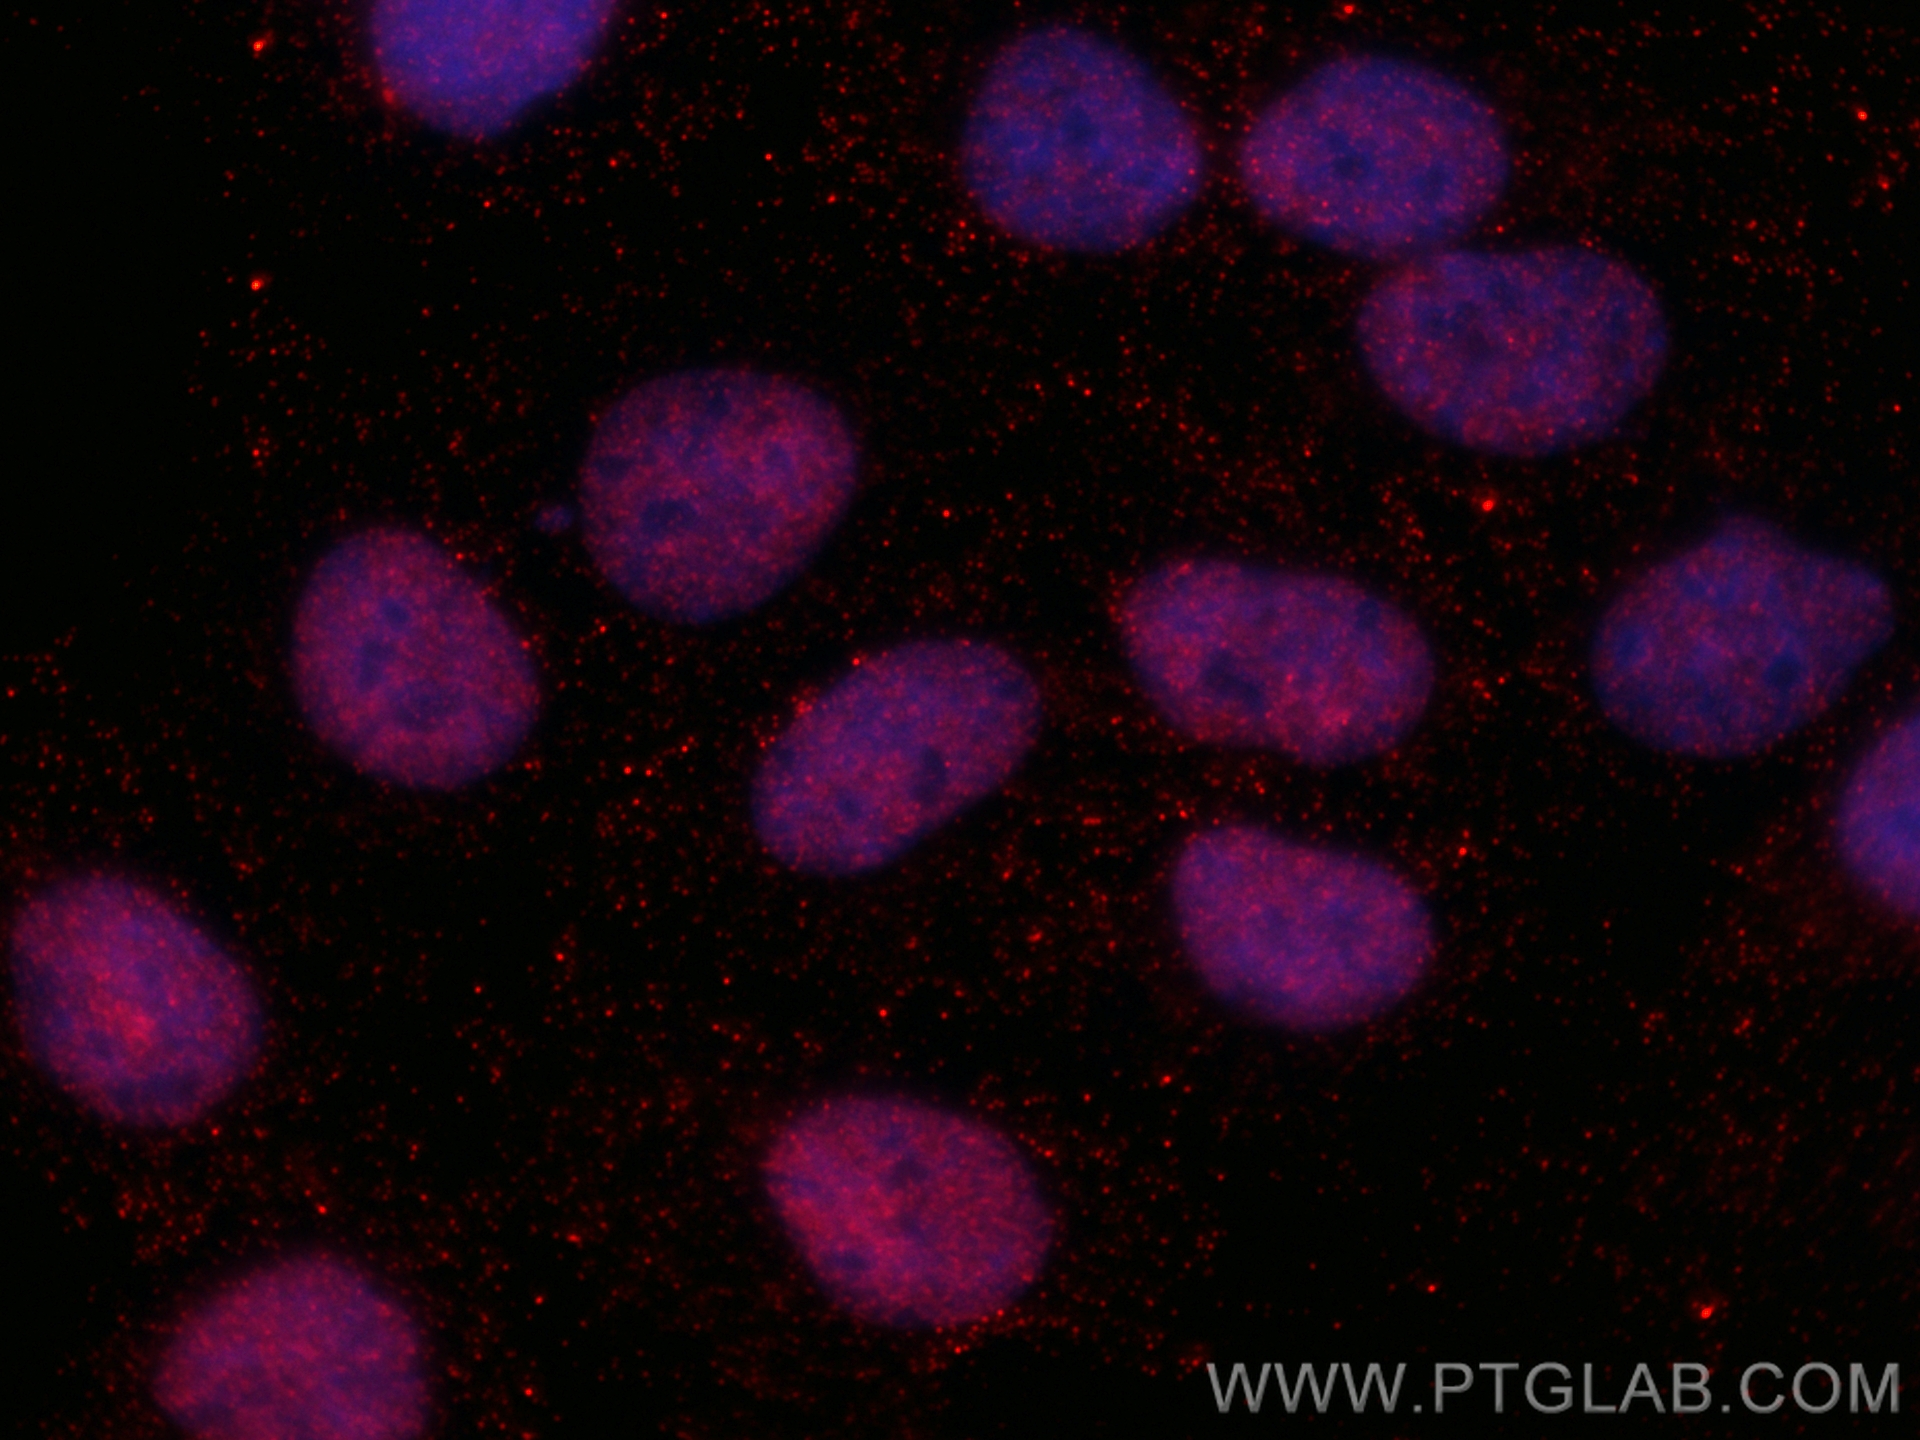

验证数据展示
经过测试的应用
| Positive IF/ICC detected in | HEK-293 cells, U2OS cells |
推荐稀释比
| 应用 | 推荐稀释比 |
|---|---|
| Immunofluorescence (IF)/ICC | IF/ICC : 1:50-1:500 |
| It is recommended that this reagent should be titrated in each testing system to obtain optimal results. | |
| Sample-dependent, Check data in validation data gallery. | |
产品信息
CL594-66279 targets ZEB1 in IF/ICC applications and shows reactivity with human samples.
| 经测试应用 | IF/ICC Application Description |
| 经测试反应性 | human |
| 免疫原 |
CatNo: Ag17118 Product name: Recombinant human ZEB1 protein Source: e coli.-derived, PET28a Tag: 6*His Domain: 391-740 aa of BC112392 Sequence: MVQAVVLPTVGLVSPISINLSDIQNVLKVAVDGNVIRQVLENNQANLASKEQETINASPIQQGGHSVISAISLPLVDQDGTTKIIINYSLEQPSQLQVVPQNLKKENPVATNSCKSEKLPEDLTVKSEKDKSFEGGVNDSTCLLCDDCPGDINALPELKHYDLKQPTQPPPLPAAEAEKPESSVSSATGDGNLSPSQPPLKNLLSLLKAYYALNAQPSAEELSKIADSVNLPLDVVKKWFEKMQAGQISVQSSEPSSPEPGKVNIPAKNNDQPQSANANEPQDSTVNLQSPLKMTNSPVLPVGSTTNGSRSSTPSPSPLNLSSSRNTQGYLYTAEGAQEEPQVEPLDLSL 种属同源性预测 |
| 宿主/亚型 | Mouse / IgG1 |
| 抗体类别 | Monoclonal |
| 产品类型 | Antibody |
| 全称 | zinc finger E-box binding homeobox 1 |
| 别名 | 1H1F1, AREB6, NIL2A, NIL-2-A zinc finger protein, TCF8 |
| 计算分子量 | 1125 aa, 124 kDa |
| 观测分子量 | 190-200 kDa |
| GenBank蛋白编号 | BC112392 |
| 基因名称 | ZEB1 |
| Gene ID (NCBI) | 6935 |
| 偶联类型 | CoraLite®594 Fluorescent Dye |
| 最大激发/发射波长 | 588 nm / 604 nm |
| 激发激光 | Yellow-Green Laser (561 nm) |
| 形式 | Liquid |
| 纯化方式 | Protein G purification |
| UNIPROT ID | P37275 |
| 储存缓冲液 | PBS with 50% glycerol, 0.05% Proclin300, 0.5% BSA, pH 7.3. |
| 储存条件 | Store at -20°C. Avoid exposure to light. Stable for one year after shipment. Aliquoting is unnecessary for -20oC storage. |
背景介绍
ZEB1(zinc-finger-enhancer binding protein 1), which is a members of the Zincfinger-Homeobox (ZFH)-family of repressors, acts as a transcriptional repressor that inhibits interleukin-2 (IL-2) gene expression. Depending on the quantity of cDNA and on the cell type, ZEB1 can enhance or repress the promoter activity of the ATP1A1 gene . Represses E-cadherin promoter and induces an epithelial-mesenchymal transition (EMT) by recruiting SMARCA4/BRG1. Represses BCL6 transcription in the presence of the corepressor CTBP1. Positively regulates neuronal differentiation. The calculated molecular weight of ZEB1 is 124 kDa, but the post phosphorylation of protein is about 190-210 kDa.
实验方案
| Product Specific Protocols | |
|---|---|
| IF protocol for CL594 ZEB1 antibody CL594-66279 | Download protocol |
| Standard Protocols | |
|---|---|
| Click here to view our Standard Protocols |